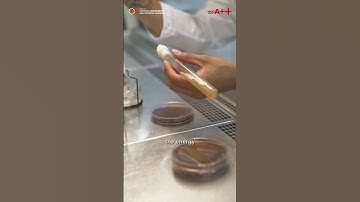
Prof. Kailash C Juglan , Dean, School of Chemical Engineering & Physical Sciences

⬇ DOWNLOAD NOW
Kalau muncul iklan pop-up, tutup lalu klik tombol kembali
Download lagu Message from the Ag. Dean - Faculty of Physical Sciences, Engineering and Technology secara gratis hanya untuk keperluan promosi. Dukung artis favorit kamu dengan membeli musik original di iTunes atau platform resmi lainnya.
 A welcome message from the Executive Dean of our Faculty of Engineering and Physical Sciences
A welcome message from the Executive Dean of our Faculty of Engineering and Physical Sciences
 CHUKA UNIVERSITY MESSAGE FROM THE DEAN, FACULTY OF SCIENCE, ENGINEERING & TECHNOLOGY
CHUKA UNIVERSITY MESSAGE FROM THE DEAN, FACULTY OF SCIENCE, ENGINEERING & TECHNOLOGY
 Welcome message from Physical Science and Engineering (PSE) Division Dean Chan
Welcome message from Physical Science and Engineering (PSE) Division Dean Chan
 Prof. Kailash C Juglan ,Associate Dean ,School of Chemical Engineering & Physical Sciences
Prof. Kailash C Juglan ,Associate Dean ,School of Chemical Engineering & Physical Sciences
 Faculty of Engineering Built Environment and Information Technology: Message from the Dean #ChooseUP
Faculty of Engineering Built Environment and Information Technology: Message from the Dean #ChooseUP
Prof. Kailash C Juglan , Dean, School of Chemical Engineering & Physical Sciences
Prof. Kailash C Juglan , Dean, School of Chemical Engineering & Physical Sciences
 UP Faculty of Natural & Agricultural Sciences: Message from the Dean #ChooseUP
UP Faculty of Natural & Agricultural Sciences: Message from the Dean #ChooseUP
 Dean of International for the Physical Sciences and Engineering College.
Dean of International for the Physical Sciences and Engineering College.